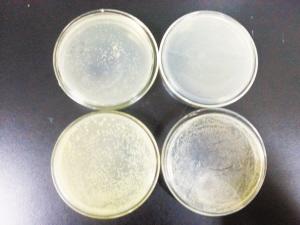

毛巾长久不换堪比“细菌炸弹” 建议用微波炉消毒
参与互动(0)

通过实验可以看到,使用时间越长,毛巾上细菌数量越多。
近日召开的中国家纺大会上,有专家提出,毛巾使用越久,越易滋生细菌,使用三个月的毛巾如果不消毒,细菌数目可能达到上万,堪称“细菌炸弹”。12月23日,河北师范大学微生物研究室通过实验,告诉您用什么方法给毛巾消毒最有效。
采样
选了四条毛巾
12月22日早晨,记者来到石家庄某小区,进行了随机采样。
【样品一:高女士家,使用二个月的洗脸毛巾】
【样品二:高女士家,使用六个月擦完脸又擦手毛巾】
【样品三:杜女士家,使用了一年的擦脸毛巾】
【样品四:王阿姨家,孩子使用了15天的擦脚毛巾】
实验①
毛巾上细菌数最高上百万个
记者带着这四条毛巾,来到河北师范大学微生物研究室,请专家给它们做一个细菌培养实验。
实验员分别从4条毛巾上,各剪掉大约2厘米见方的毛巾样品,浸泡于无菌生理盐水的试管中,再放入恒温培养箱,24小时后,12月23日上午,结果出来了:高女士家用了两个月的毛巾菌落稍微少一些,而她家使用六个月擦完脸又擦手毛巾,以及杜女士家用了一年的毛巾,菌落都是非常多。
高女士家使用了两个多月的擦脸毛巾,菌落数最少,大概40多个;而高女士家那条使用了六个多月,擦完脸又改为擦手的毛巾,菌落数却达到400多个。杜女士家使用了近一年的毛巾,菌落数多达400多个。王阿姨家孩子的擦脚毛巾,虽然只使用了15天,但菌落数居然也多达500多个。
实验员介绍,这只是大约2厘米见方的毛巾的细菌培养,如果是整条毛巾,细菌数将多达十几万甚至上百万个。
实验②
微波炉高温杀菌效果最好
那么,哪种消毒方式最有效呢?河北师范大学微生物研究室也通过实验来证实。
实验结果:把毛巾放到微波炉专用保鲜盒内,调到高火3到5分钟,测试发现毛巾的菌落数杀灭率达98%。
而把毛巾放到沸水煮5分钟,只能杀死一般细菌的繁殖体。
毛巾放到高压锅内汽蒸,温度达120℃-150℃,需要蒸10-15分钟,才能100%灭菌。
鞠建松介绍,用沸水煮和高压锅汽蒸,会影响毛巾的色牢度和强度,不建议经常使用。而微波消毒效果可靠,杀菌快,且无化学消毒剂不良反应,是比较理性的消毒方法,建议应每7到10天就对毛巾高温消毒一次。
建议
2到3个月更换一次毛巾
河北师范大学生命科学学院鞠建松教授介绍,很多人经常是毛巾破损了才舍得扔,或者一条毛巾“身兼数职”,洗脸、擦手、洗澡、洗头。对于使用频率高的毛巾来说,绝对是“致命一击”。人们通常习惯把毛巾放在卫生间里,而由于纯棉制成的毛巾吸湿、储水性特别好,这就为细菌的滋生提供了“温床”,再加上空气中灰尘、皮肤油脂、外界病菌的侵扰,会让毛巾越用越脏。
那么为什么孩子仅仅用了15天左右的擦脚毛巾,细菌也如此多呢?“可能跟脚部的环境有关,儿童的脚长时间处于比较潮湿、闷热的环境中,孩子的活动量又大,微生物很容易滋生,所以擦脚毛巾上有很多细菌。”鞠建松说,另外干燥的环境,并不是微生物就不生长了,而是微生物处在一个休眠的状态里,一旦他要是洗完脚擦脚,毛巾就会潮湿了,微生物就会大量滋生起来,所以不能认为仅仅保持干燥就行。
鞠建松还介绍,大量细菌沉积在毛巾上,再用这样的毛巾擦拭皮肤,不仅起不到清洁的作用,反而会玷污皮肤、堵塞毛孔,还可能引起不适,尤其是孩子和过敏体质的人,更容易中招。“在保持毛巾卫生上,我建议毛巾从用途上来分,最好每人准备三块毛巾,另外提倡大家,尽量2到3个月更换一次毛巾。”
>社会新闻精选:




















